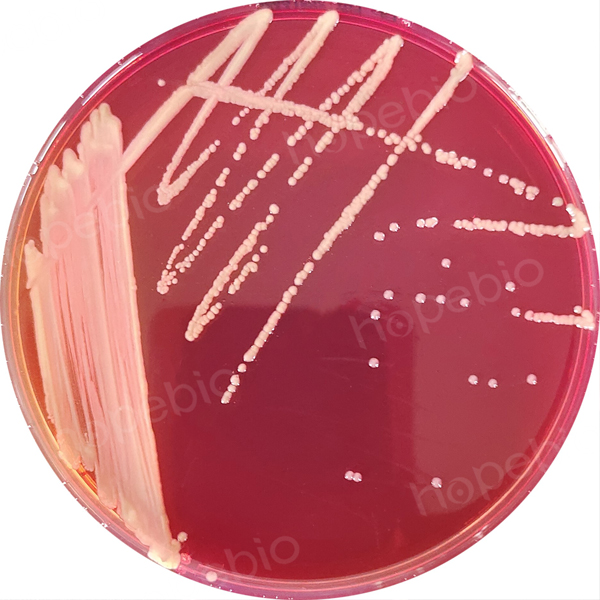

海博微信公众号
海博微信公众号
 海博天猫旗舰店
海博天猫旗舰店


 海博微信公众号
海博微信公众号
 海博天猫旗舰店
海博天猫旗舰店




一、洋葱伯克霍尔德菌简介
洋葱伯克霍尔德菌(Burkholderia cepacia)(1950年Burkholder首次自洋葱根部分离)因引起洋葱腐烂而得名,原归类假单胞菌属,定名为洋葱假单胞菌。1992年,Yabuuchi等正式将该菌与类鼻疽伯克霍尔德菌、唐菖蒲伯克霍尔德菌、皮氏伯克霍尔德菌和鼻疽伯克霍尔德菌等归为一个新属,即伯克霍尔德菌属。该菌在医院环境中广泛存在,尤其在囊性纤维化(cystic fibrosis,CF)和慢性肉芽肿病(chronic granulomatous disease,CGD)患者痰液中易分离到。目前国内外研究资料提示该菌临床分离率不断增加,且对现有的抗菌药物具有较高的耐药性。
洋葱伯克霍尔德菌是一种带尾丝革兰阴性杆菌,在血平板上菌落呈淡黄色,湿润、凸起、浑浊,不溶血;麦康凯平板上为乳糖不发酵菌落,细小而清晰,延长培养48h后中心呈粉红色。
二、参考标准
《SN/T 4684-2016 进出口化妆品中洋葱伯克霍尔德菌检验方法》
三、检验程序
洋葱伯克霍尔德菌检验程序见图1。

图1 洋葱伯克霍尔德菌检验程序
四、操作步骤和结果判断
4.1 增菌培养
按照GB 7918.1方法制备1:10化妆品稀释液,取稀释液10mL加到90mL含多粘菌素B的SCDLP增菌液中,于36℃±1℃培养24h,移取1mL,转种于10mL含庆大霉素的BCSA增菌液内,于36℃±1℃培养18 h~24 h。
含多粘菌素B的SCDLP增菌液原理:酪蛋白胨和大豆蛋白胨提供微生物生长所需的氮源、维生素和生长因子;氯化钠维持均衡的渗透压;磷酸氢二钾为培养基pH的缓冲剂;葡萄糖为可发酵的糖类;卵磷脂和吐温80能中和防腐剂,并能起到在乳浊液中分散物质的功能,卵磷脂能中和季铵盐,吐温80可中和酚、六氯酚、福尔马林,两者结合可中和乙醇;多粘菌素B可抑制铜绿假单胞菌和其他伯克霍尔德菌生长。
用法:称取本品31.0g,另取吐温80 7.0g加热溶解于1000mL蒸馏水中,分装,121℃高压灭菌20分钟,冷却,使用前,按每100mL培养基中加入过滤除菌的多粘菌素B 25000U,混匀,备用。
洋葱伯克霍尔德菌在含多粘菌素B的SCDLP增菌液中生长良好,结果如图2所示:

图2 在含多粘菌素B的SCDLP增菌液中的生长情况
含庆大霉素的BCSA增菌液原理:酪蛋白胨、酵母提取物提供细菌生长的基本营养;氯化钠维持渗透压;庆大霉素为广谱抗生素,对多数假单胞菌属、变形杆菌属、大肠菌群、葡萄球菌属、需氧芽孢杆菌属等多种革兰氏阴阳性菌有较强的抗菌活性,结晶紫主要抑制革兰氏阳性菌和念珠菌的生长;乳糖和蔗糖为可发酵碳源;酚红为酸碱指示剂,洋葱伯克霍尔德氏菌可氧化发酵蔗糖产少量酸,不发酵乳糖,生长时培养基微变黄色。
用法:称取本品36.58g,加热煮沸,完全溶解于1000mL蒸馏水中,分装三角瓶或试管,115℃高压灭菌15分钟,使用前,按每100mL培养基中加入过滤除菌的庆大霉素1mg,混匀,备用。
洋葱伯克霍尔德菌在含庆大霉素的BCSA增菌液中生长良好,结果如图3所示:

图3 在含庆大霉素的BCSA增菌液中的生长情况
4.2 分离培养
分别用接种环取BCSA增菌液一环,划线接种于BCSA琼脂(含多粘菌素B、庆大霉素)平板和麦康凯琼脂(含多粘菌素B、庆大霉素)平板,于32℃±1℃培养48 h,观察各个平板上生长的菌落。
含多粘菌素B、庆大霉素的BCSA琼脂原理:酪蛋白胨、酵母提取物提供细菌生长的基本营养;氯化钠维持渗透压;庆大霉素为广谱抗生素,对多数假单胞菌属、变形杆菌属、大肠菌群、葡萄球菌属、需氧芽孢杆菌属等多种革兰氏阴阳性菌有较强的抗菌活性;结晶紫主要抑制革兰氏阳性菌和念珠菌的生长;乳糖和蔗糖为可发酵碳源;酚红为酸碱指示剂,洋葱伯克霍尔德氏菌可氧化发酵蔗糖产少量酸,不发酵乳糖,生长时培养基微变黄色。
USP42标准中洋葱伯克霍尔德氏菌特征为生长带有黄色光环的绿棕色菌落,或被粉红色区域包围的白色菌落。
用法:称取本品50.58g,加热煮沸,完全溶解于1000mL蒸馏水中,分装三角瓶,115℃高压灭菌15分钟,冷却至50℃左右时,按每100mL培养基中加入过滤除菌的多粘菌素B 60000U和庆大霉素1mg,混匀,倾入无菌平皿,备用。
洋葱伯克霍尔德菌在含多粘菌素B、庆大霉素的BCSA琼脂平板上的菌落为菌落呈淡黄色至淡红色,表面光滑,周围培养基变红,结果如图4所示:
洋葱伯克霍尔德菌ATCC 25416
图4 BCSA琼脂(含多粘菌素B、庆大霉素)平板上的菌落特征
含多粘菌素B、庆大霉素的麦康凯琼脂原理:蛋白胨提供细菌生长的基本营养;氯化钠维持渗透压;多粘菌素B主要抑制多数革兰氏阴性细菌的生长,庆大霉素为广谱抗生素,对多种革兰氏阴性菌和阳性菌均有抑制作用;牛胆盐主要可抑制革兰氏阳性菌的生长;乳糖为可发酵碳源;中性红为酸碱指示剂,洋葱伯克霍尔德氏菌不发酵乳糖,菌落通常呈黄褐色或微红色,周围培养基通常不变色或因产碱变为橙黄色,而发酵乳糖的杂菌在培养基上则呈现桃红色,菌落周围可有沉淀环,与洋葱伯克霍尔德氏菌区分开来。
用法:称取本品54.03g,加热煮沸,完全溶解于1000mL蒸馏水中,分装三角瓶,115℃高压灭菌20分钟,冷却至50℃左右时,按每100mL培养基中加入过滤除菌的多粘菌素B 25000U和庆大霉素1mg,混匀,倾入无菌平皿,备用。
洋葱伯克霍尔德菌在含多粘菌素B、庆大霉素的麦康凯琼脂平板上的典型菌落为浅黄褐色圆形菌落,表面光滑,周围培养基通常不变色或因产碱变为橙黄色,结果如图5所示:

洋葱伯克霍尔德菌ATCC 25416
图5 麦康凯琼脂(含多粘菌素B、庆大霉素)平板上的菌落特征
4.3 鉴定
4.3.1 初筛
自选择性琼脂平板上分别挑取5个以上典型或可疑菌落,同一菌株接种于2支葡萄糖氧化/发酵管,其中一支加灭菌液体石蜡封口,另一支不封口,于36℃±1℃培养24h,二者均变黄为葡萄糖发酵型,未加石蜡管变黄而加石蜡管不变色为葡萄糖氧化型。同时在营养琼脂平板上划线纯化,于36℃±1℃培养24 h,选择葡萄糖氧化型(加石蜡管不变黄,不加石蜡管变黄)的纯培养物继续进行鉴定;洋葱伯克霍尔德菌的葡萄糖生化管结果如图6所示。

图6 葡萄糖氧化/发酵管试验结果
4.3.2 革兰氏染色
挑取可疑菌落涂片,进行革兰氏染色。显微镜下观察,洋葱伯克霍尔德菌为革兰氏阴性杆菌,如图7所示。

图7 革兰氏染色镜检结果
4.3.3 氧化酶试验
用玻璃棒或一次性接种针挑取单个特征性菌落,涂布在氧化酶试剂湿润的滤纸平板上。洋葱伯克霍尔德菌为迟缓型氧化酶阳性(紫红色、紫色或深蓝色),反应时间约为2min~10min,如图8所示。
注:实验中切勿使用镍/铬材料。

图8 氧化酶试验结果
4.3.4 过氧化氢酶试验
用玻璃棒或一次性接种针挑取单个特征性菌落,置于洁净载玻片上,滴加3%过氧化氢溶液,观察气泡产生情况。洋葱伯克霍尔德菌为迟缓产气,1s后缓慢出现气泡,如图9所示。

图9 过氧化氢酶试验结果
4.3.5 蔗糖氧化
挑取可疑菌落接种于蔗糖氧化培养基,36℃±1℃培养24h,培养基变黄色为阳性。洋葱伯克霍尔德菌为阳性反应,如图10所示。

图10 蔗糖氧化试验结果
4.3.6 枸橼酸盐利用
挑取可疑菌落接种于西蒙氏枸橼酸盐培养基,36℃±1℃培养24h,培养基变蓝色为阳性,绿色为阴性。洋葱伯克霍尔德菌为阳性反应,如图11所示。

图11 西蒙氏枸橼酸盐利用结果
4.3.7 七叶苷利用
挑取可疑菌落接种于七叶苷培养基,30℃±1℃培养24h,培养基变黑色为阳性,不变色为阴性。洋葱伯克霍尔德菌为阳性反应,如图12所示。

图12 七叶苷利用结果
4.3.8 替代试验
可选择生化鉴定试剂盒或全自动微生物生化鉴定系统,根据4.3.1的初步判断结果,对可疑菌落进行鉴定。
4.4 结果报告
综合以上试验结果,报告10g(mL)样品中检出或未检出洋葱伯克霍尔德菌。
五、附录:
《GB/T 7918.1-1987 化妆品微生物标准检验方法 总则》样品处理方法

相关标准:
GB/T 7918.1-1987 化妆品微生物标准检验方法 总则 点击下载
SNT4684-2016进出口化妆品洋葱伯克霍尔德菌检验方法 点击下载
注:本文属海博生物原创,未经允许不得转载。
下一篇:生化鉴定条使用注意事项及讨论



